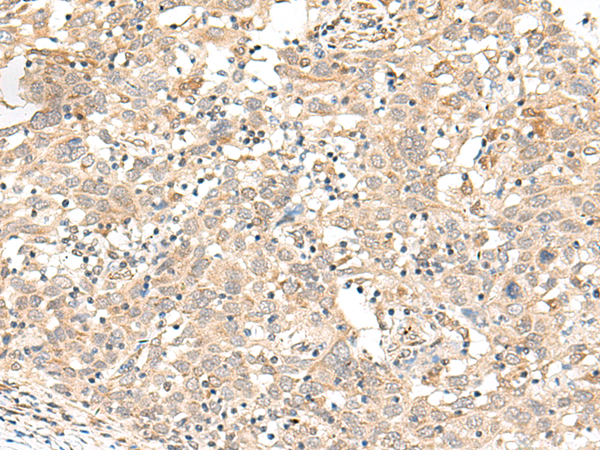
一抗

中文名稱: 兔抗FUT3多克隆抗體
相關(guān)類別: 一抗
抗 原: FUT3
儲(chǔ) 存: 冷凍(-20℃)
宿 主: Rabbit
反應(yīng)種屬: Human
標(biāo) 記 物: Unconjugate
克隆類型: rabbit polyclonal
技術(shù)規(guī)格
|
Background: |
The Lewis histo-blood group system comprises a set of fucosylated glycosphingolipids that are synthesized by exocrine epithelial cells and circulate in body fluids. The glycosphingolipids function in embryogenesis, tissue differentiation, tumor metastasis, inflammation, and bacterial adhesion. They are secondarily absorbed to red blood cells giving rise to their Lewis phenotype. This gene is a member of the fucosyltransferase family, which catalyzes the addition of fucose to precursor polysaccharides in the last step of Lewis antigen biosynthesis. It encodes an enzyme with alpha(1,3)-fucosyltransferase and alpha(1,4)-fucosyltransferase activities. Mutations in this gene are responsible for the majority of Lewis antigen-negative phenotypes. Multiple alternatively spliced variants, encoding the same protein, have been found for this gene. |
|
Applications: |
ELISA, IHC |
|
Name of antibody: |
FUT3 |
|
Immunogen: |
Synthetic peptide of human FUT3 |
|
Full name: |
fucosyltransferase 3 (Lewis blood group) |
|
Synonyms: |
LE; Les; FT3B; CD174; FucT-III |
|
SwissProt: |
P21217 |
|
ELISA Recommended dilution: |
5000-10000 |
|
IHC positive control: |
Human cervical cancer and Human ovarian cancer |
|
IHC Recommend dilution: |
40-200 |


 購物車
購物車 幫助
幫助
 021-54845833/15800441009
021-54845833/15800441009